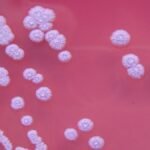
డిజిటల్ అరెస్ట్ అనేది సైబర్ మోసం : జిల్లా ఎస్పీ అశోక్ కుమార్ ఐపీఎస్

దీని పట్ల ప్రజలు అప్రమత్తంగా ఉండాలి
సెప్టెంబర్ 23 పున్నమి ప్రతినిధి @
డిజిటల్ అరెస్ట్ అనేది పూర్తిగా ఒక సైబర్ మోసం. దీనిని ఎవరూ నమ్మవద్దు అని డిజిటల్ అరెస్ట్ పేరిట జరుగుతున్న మోసాలపై ప్రజలు అప్రమత్తంగా ఉండాలి అని జిల్లా ఎస్పి అశోక్ కుమార్ ఐపిఎస్ అన్నారు. డిజిటల్ అరెస్ట్ మోసం అంటే సైబర్ నేరగాళ్లు తాము పోలీస్ అధికారులు, సీబీఐ, ఎన్ఫోర్స్మెంట్ డైరెక్టరేట్ లేదా ఇతర ప్రభుత్వ విభాగాల సిబ్బంది అన్నట్లుగా నటిస్తూ, మీపై కేసు ఉందని భయపెట్టడం, వీడియో కాల్ లో అరెస్ట్ చేస్తున్నాం అని చూపించడం, డబ్బులు బదిలీ చేస్తే తప్పించుకుంటారని మోసం చేయడం వంటి నేరాలు పెరుగుతున్న నేపద్యంలో ఇలాంటి నేరాలను నివారించడానికి ప్రజలు కు అవగాహన తప్పనిసరి అన్నారు. డిజిటల్ అరెస్ట్ మోసానికి గురైన వెంటనే 1930 నంబర్ కి కాల్ చేస్తే డబ్బు తిరిగి రికవరీ అయ్యే అవకాశం ఉంటుంది. ఆలస్యం చేస్తే నష్టపోవాల్సిందే అని తెలిపారు.
డిజిటల్ అరెస్ట్ మోసాల పట్ల ప్రజలకు జిల్లా పోలీసుల సూచనలు:
1. ఎలాంటి ప్రభుత్వ శాఖలు లేదా పోలీసులు డబ్బులు అడగరు.
2. మీపై కేసులు ఉన్నాయన్న కారణంగా ఎవరైనా వీడియో కాల్ ద్వారా బెదిరిస్తే నమ్మకండి.
3. వెంటనే 1930 నెంబర్ (సైబర్ క్రైమ్ హెల్ప్లైన్) లేదా 100 నెంబర్ కు కాల్ చేసి ఫిర్యాదు చేయాలి.
4. మోసపూరిత కాల్స్, మెసేజెస్, వాట్సాప్ వీడియో కాల్స్ కు స్పందించవద్దు.
5. ఈ రకమైన నేరాల నుండి రక్షించుకోవడానికి ప్రతి ఒక్కరూ సైబర్ సేఫ్టీ పై అవగాహన పెంపొందించుకోవాలి.